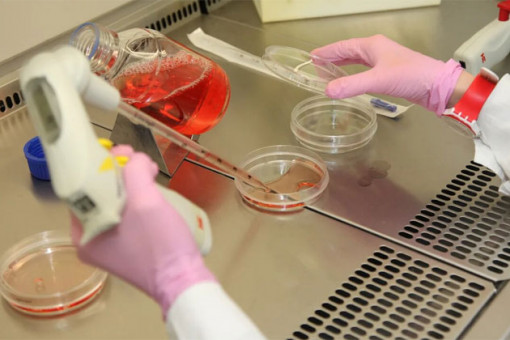

НАУКА
23.07.2020
Новосибирские генетики доказали – человеческий гормон меланин содержат многие растения. Более того, представители флоры умеют общаться друг с другом. Статью опубликовали в авторитетном научном журнале, а на экспериментальные поля высадили разноцветный ячмень, который получился в результате генетических изменений.
22.07.2020
Флагман программы «Академгородок 2.0» Сибирский кольцевой источник фотонов должны построить в срок. Новосибирские вузы могут получить новый статус, а студенты начнут новый учебный год в привычном очном формате. Подведены итоги рабочего визита министра науки и высшего образования РФ Валерия Фалькова в Новосибирскую область.
21.07.2020
Принципиальных сложностей в реализации проекта СКИФ нет, набраны хорошие темпы его реализации. Необходимо выполнить архитектурное решение здания СКИФ и продумать развитие территорий под вторую очередь реализации проекта СКИФ. Еще один приоритет - развитие инфраструктуры Новосибирского государственного исследовательского университета. В ходе совместной пресс-конференции министр науки и образования РФ Валерий Фальков и губернатор Новосибирской области Андрей Травников ответили на вопросы журналистов по итогам рабочей поездки министра в регион.
21.07.2020
Евразийский вирусологический центр будет создан на базе Федерального исследовательского центра фундаментальной и трансляционной медицины СО РАН. Специалисты центра будут работать с микроорганизмами-возбудителями опасных заболеваний.
21.07.2020
Новый род африканских пауков описала новосибирская исследовательница из Института систематики и экологии животных СО РАН Галина Азаркина. Результаты исследования опубликованы в European Journal of Taxonomy.
21.07.2020
Новосибирские ученые создали полупроводник толщиной всего один нанометр. Это значительно тоньше человеческого волоса. Пленку из металлов и неметаллов выращивают в лаборатории. Ученые доказали, что ток в таком материале течет по законам квантовой физики. Электроны практически не теряют энергию при движении.
15.07.2020
Ученые новосибирского Академгородка выделили антитела, нейтрализующие коронавирус SARS-CoV-2. Развитие работ в этом направлении позволит создать лекарство и вакцину против коронавирусной инфекции нового типа.
14.07.2020
Студентка магистратуры НГТУ получила медаль Российской академии наук. Престижную награду ей дали за разработку, которая позволит обеспечить стабильность работы Сибирского кольцевого источника фотонов. Данная разработка поможет создать максимально качественный пучок частиц, необходимый для современных экспериментов.
14.07.2020
Новосибирские ученые разработали программу, которая позволяет быстро и точно подобрать лечение для людей с гипертонией. В ее основе – методы математического моделирования. Программа уже вышла на этап клинических испытаний.
14.07.2020
В новосибирском серпентарии планируют производить субстанцию из яда моноклевых кобр. В перспективе ее можно будет использовать для изготовления лечебных и косметических мазей. Сейчас центр специализируется преимущественно на гадюках. Яд этих змей покупают фармкомпании по всему миру.
06.07.2020
Сибирские генетики получили неожиданный результат - вывели свиней с пятью пальцами. Животных выводят с определенной целью - опробовать новые медицинские технологии. Им делают операции, которые в будущем помогут людям.
02.07.2020
Большой парад планет состоится в июле в нашей Солнечной системы. В июле 2020 года в нем примут участие Меркурий, Венера, Марс, Юпитер, Сатурн, Уран и Нептун. Можно ли и как наблюдать это явление?
30.06.2020
Когда вакцину начнут испытывать на людях и сколько времени продлятся эти испытания, рассказал генеральный директор новосибирского центра «Вектор» Ринат Максютов.
Новости
-
Оголодавшие землеройки вылезли из-под снега и атакуют жителей Новосибирска
-
Каждый десятый пенсионер РФ мечтает жить в Новосибирске
-
Новые платные парковки заработали с 26 декабря в Новосибирске
-
Дед Мороз, Снегурочка, снеговик, медвежонок и зайчик: новосибирская художница придумала новогодние матрешки
-
Прогноз погоды на 27-28 декабря в Новосибирске сделали синоптики
Новости районных СМИ
Новости районов
-
Экс-глава сельсовета осужден за смертельный пожар под Новосибирском
-
Огненную лошадь из озерного льда в центре Искитима ваяет новосибирец
-
Маршрут автобуса №120 Линево - Искитим отменяют с 1 января 2026 года
-
Герой СВО Михаил Карпов стал новым военкомом в трех районах под Новосибирском
-
Алиментщика привлекли в Каргате для расчистки улиц от снега
Новости партнеров
-
Выездные менеджеры Сбера в 2025 году проехали 2,7 млн км и доставили клиентам 1 млн карт
-
Более 550 тысяч юных сибиряков совершают свои первые покупки с помощью детской СберКарты
-
Каждый четвёртый платёж через терминал в 2025 году в России совершали по QR-коду, NFC или улыбке